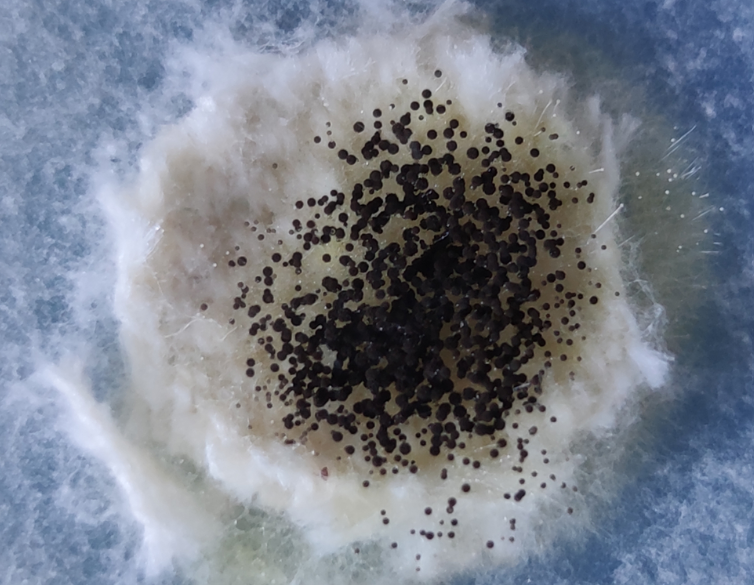

Spooky2 zeigt Wirkung – weißer Halo um Zyste deutlich zurückgegangen

„Nach nur drei Monaten Remote-Anwendung war der weiße Halo um die Zyste im MRT deutlich zurückgegangen, und weder die Zyste noch der Tumor hatten an Größe zugenommen. Ganz ohne Medikamente, nur mit gezielten Frequenzen – ein kleiner, aber wichtiger Schritt…